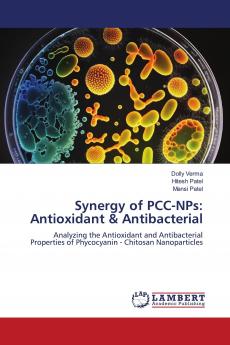
Synergy of PCC-NPs

English
Paperback
₹3728
₹3924
4.99% OFF
(All inclusive*)
Delivery Options
Please enter pincode to check delivery time.
*COD & Shipping Charges may apply on certain items.
Review final details at checkout.
Looking to place a bulk order? SUBMIT DETAILS
About The Book
Description
Author
In summary the goal of this work was achieved by successfully separating phycocyanin from Spirulina and encapsulating it in chitosan nanoparticles. The effectiveness of the phycocyanin nanoparticles' antioxidant and antibacterial characteristics was then evaluated. The nanoparticles show a significant potential for antioxidant and antibacterial action according to our data. In addition it was found that the nanoparticles were more active than the crude phycocyanin extract indicating that the formulation technique was effective. The examination of phycocyanin nanoparticles using techniques such as transmission electron microscopy dynamic light scattering and Fourier transform infrared spectroscopy yielded valuable information about the nanoparticles' physicochemical properties. The nanoparticles were spherical ranged in size from 80 to 120 nm and had a zeta potential of -30 mV according to the results. The FTIR analysis demonstrated conclusively that chitosan was included in the nanoparticle formulation.
Delivery Options
Please enter pincode to check delivery time.
*COD & Shipping Charges may apply on certain items.
Review final details at checkout.
Details
ISBN 13
9786206740551
Publication Date
-26-01-2024
Pages
-56
Weight
-90 grams
Dimensions
-150x220x3.48 mm